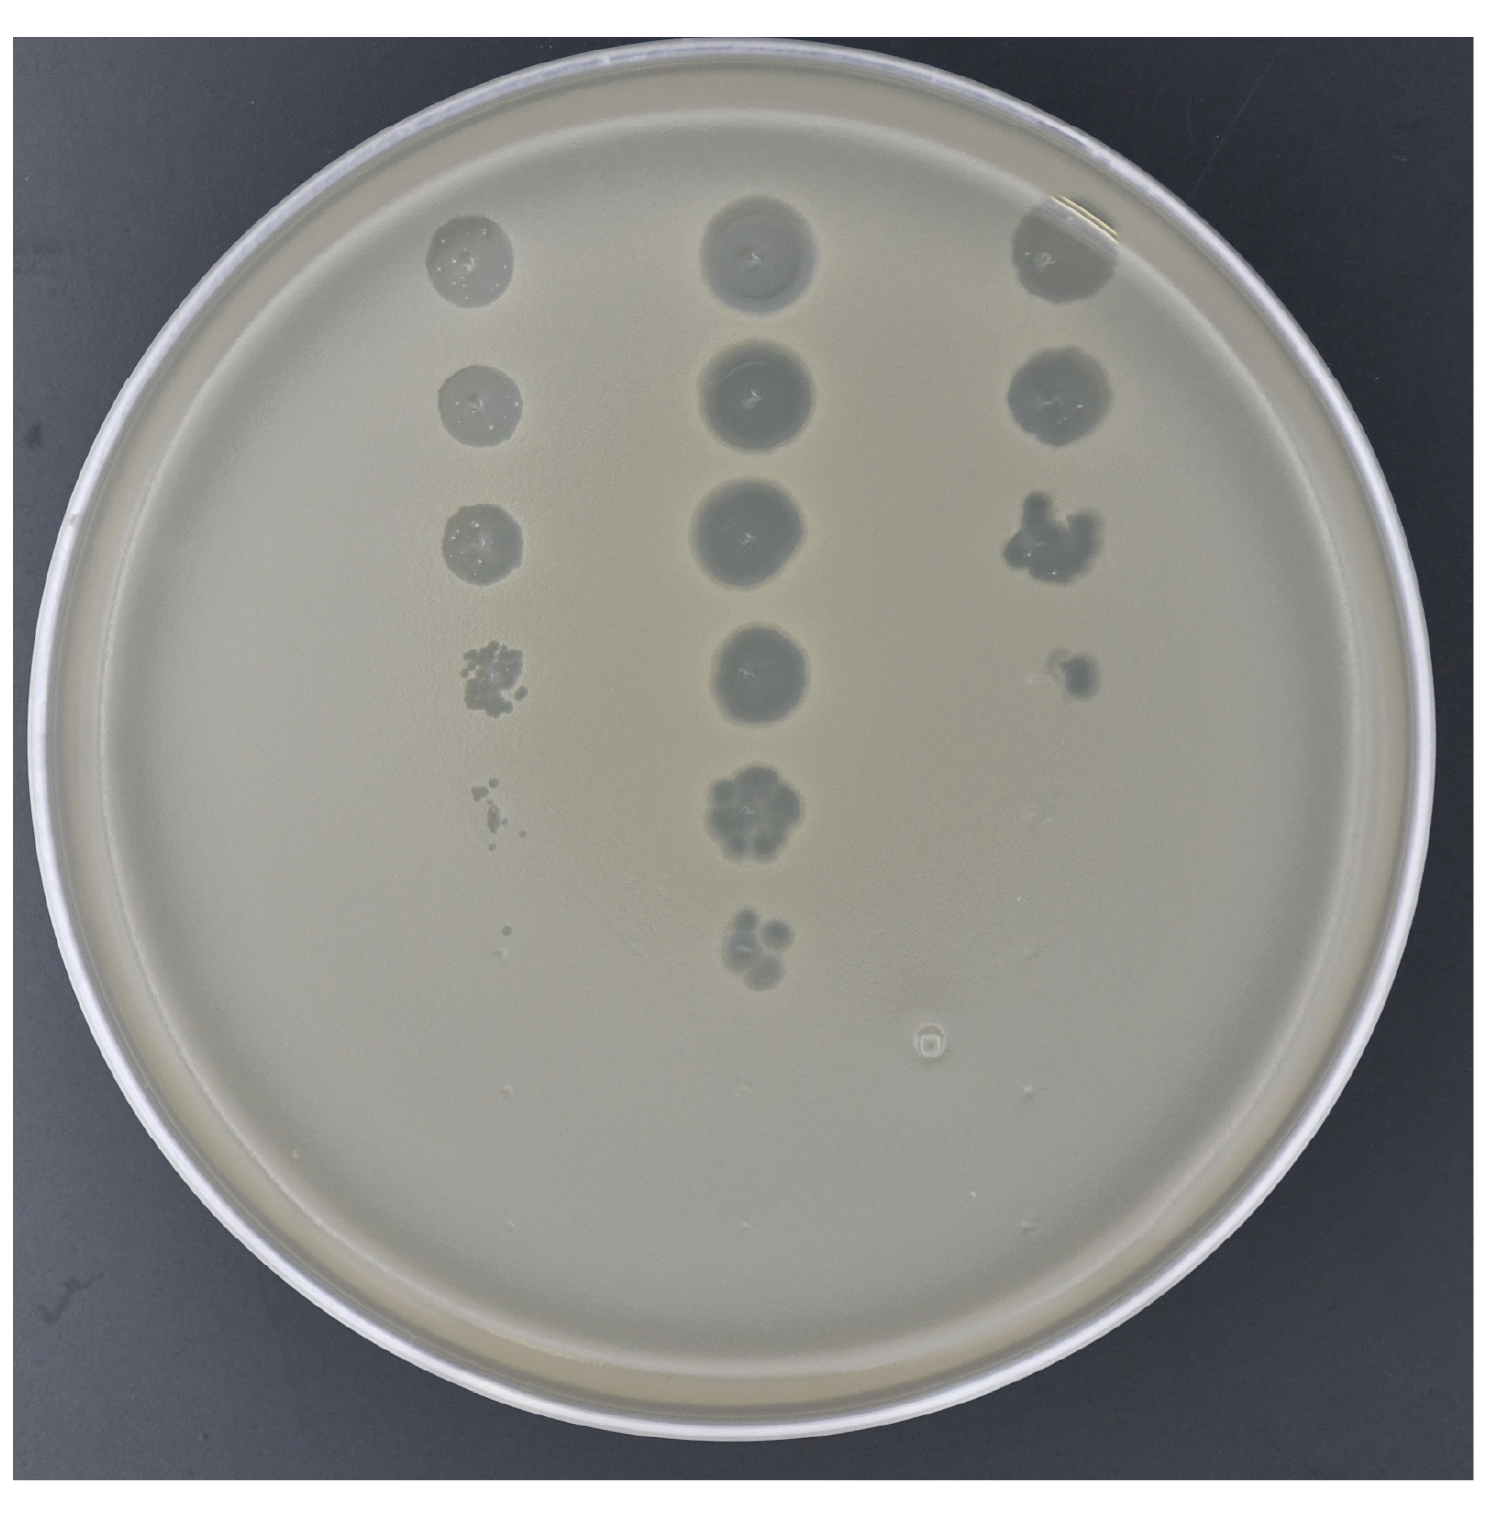

Our research


Antiviral immunity by bacterial cGAS-like pathways
Bacteria have been locked in an arms race with bacteriophages (viruses that infect bacteria) for billions of years, and in response have evolved sophisticated defense systems that bear striking resemblance to our own. A major focus of our lab is understanding how bacteria protect themselves from phage infections through genetically encoded innate systems. We primarily study cyclic oligonucleotide-based antiphage signaling systems (CBASS) which is a widespread immune pathway found in almost all known bacteria, and is the evolutionary progenitor to the human cGAS-STING pathway: a crucial player in immunity to cancer and viral infection. A central theme of our work is that the proteins and chemical signals driving these bacterial immune responses are the direct evolutionary ancestors of key components of human innate immunity. By dissecting the biochemical logic of bacterial immune systems, we aim to uncover conserved paradigms in antiviral immunity from bacteria to humans.

Membranolytic cell death effectors
Across both prokaryotic and eukaryotic innate immunity, a recurring solution to viral infection is the targeted disruption of cellular membranes a strategy executed by a remarkably diverse set of effector proteins that share a common outcome but often little sequence or structural similarity. Transmembrane immune effectors are widespread in bacterial defense systems, appearing in CBASS, CRISPR, and other antiphage pathways, yet the biochemical mechanisms by which most of these proteins disrupt membranes remain poorly understood. We primarily study STING-like transmembrane effectors form bacteria that sense cyclic dinucleotide signals and respond by perturbing membrane integrity to abort phage replication. The mechanism by which they do so is distinct from all known pore-forming channels or toxins. Our goal is to define how ligand binding is coupled to membrane disruption across this functionally diverse effector class, and what these ancient bacterial proteins reveal about the evolutionary origins of membranolytic cell death in eukaryotic immunity.

Bacteriophage virology and discovery
Viruses that infect bacteria (bacteriophages / phages) are the most abundant biological entities on Earth, yet the vast majority remain uncharacterized, representing an enormous untapped reservoir of viral diversity, novel biology, and therapeutic potential. We actively isolate and characterizes new phages from environmental samples, with the goal of understanding how phages infect bacterial hosts, hijack cellular machinery, and complete their replication cycle.. Understanding the molecular details of phage replication is not only fundamental to virology, but is essential for designing phage-based therapies that can selectively target antibiotic-resistant bacterial pathogens. As antimicrobial resistance continues to rise, we are particularly interested in developing and deploying phages as precision therapeutic agents against clinically relevant bacteria.
